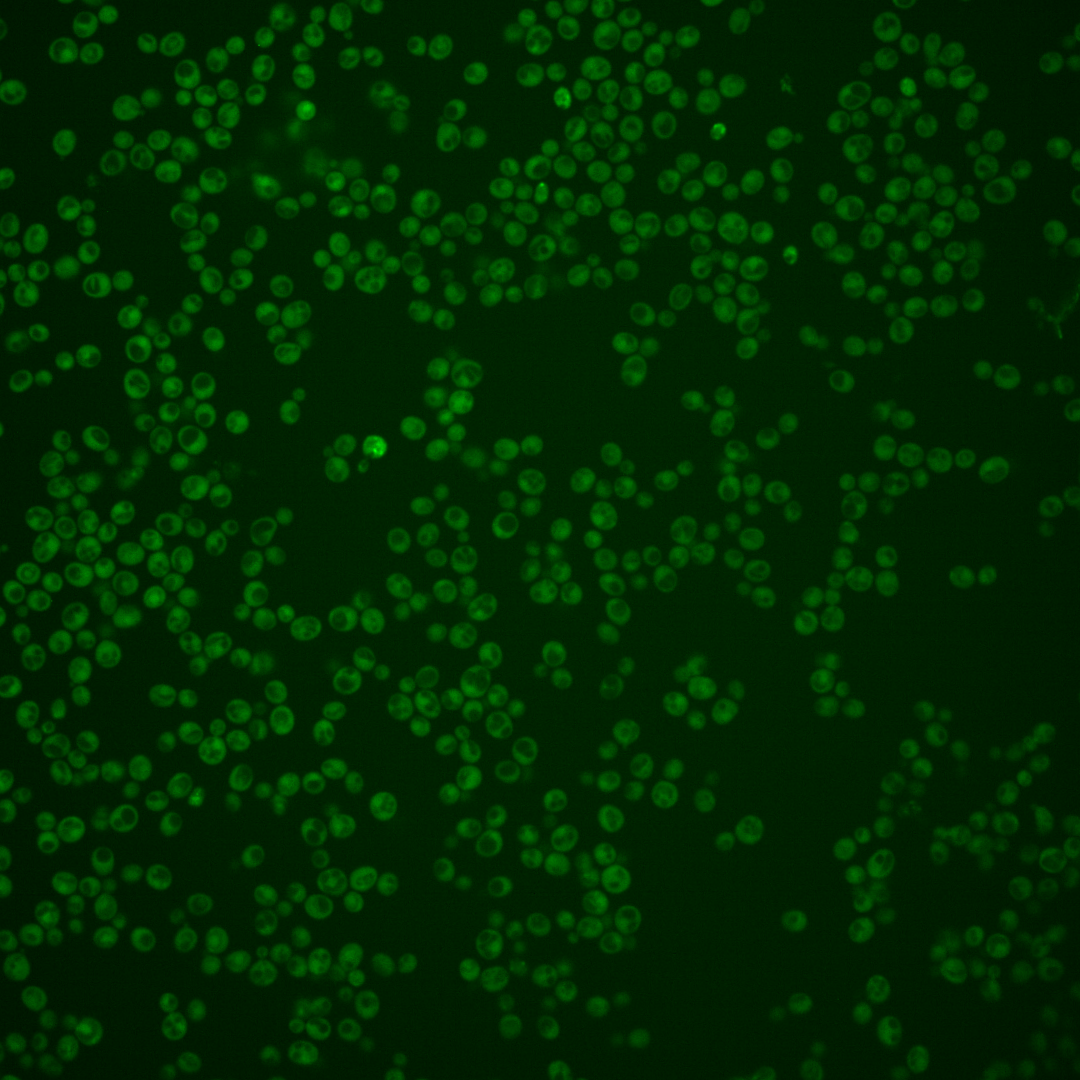
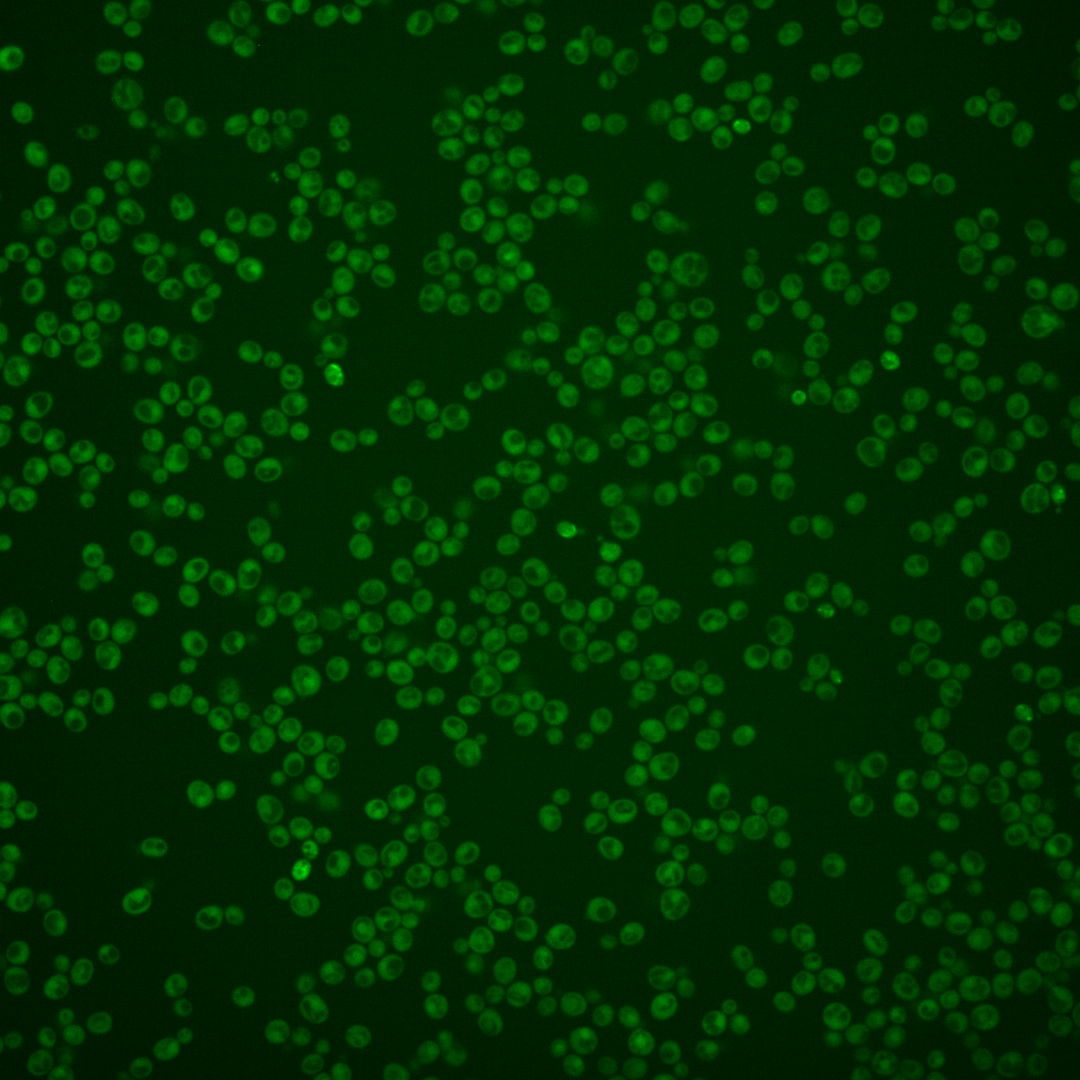
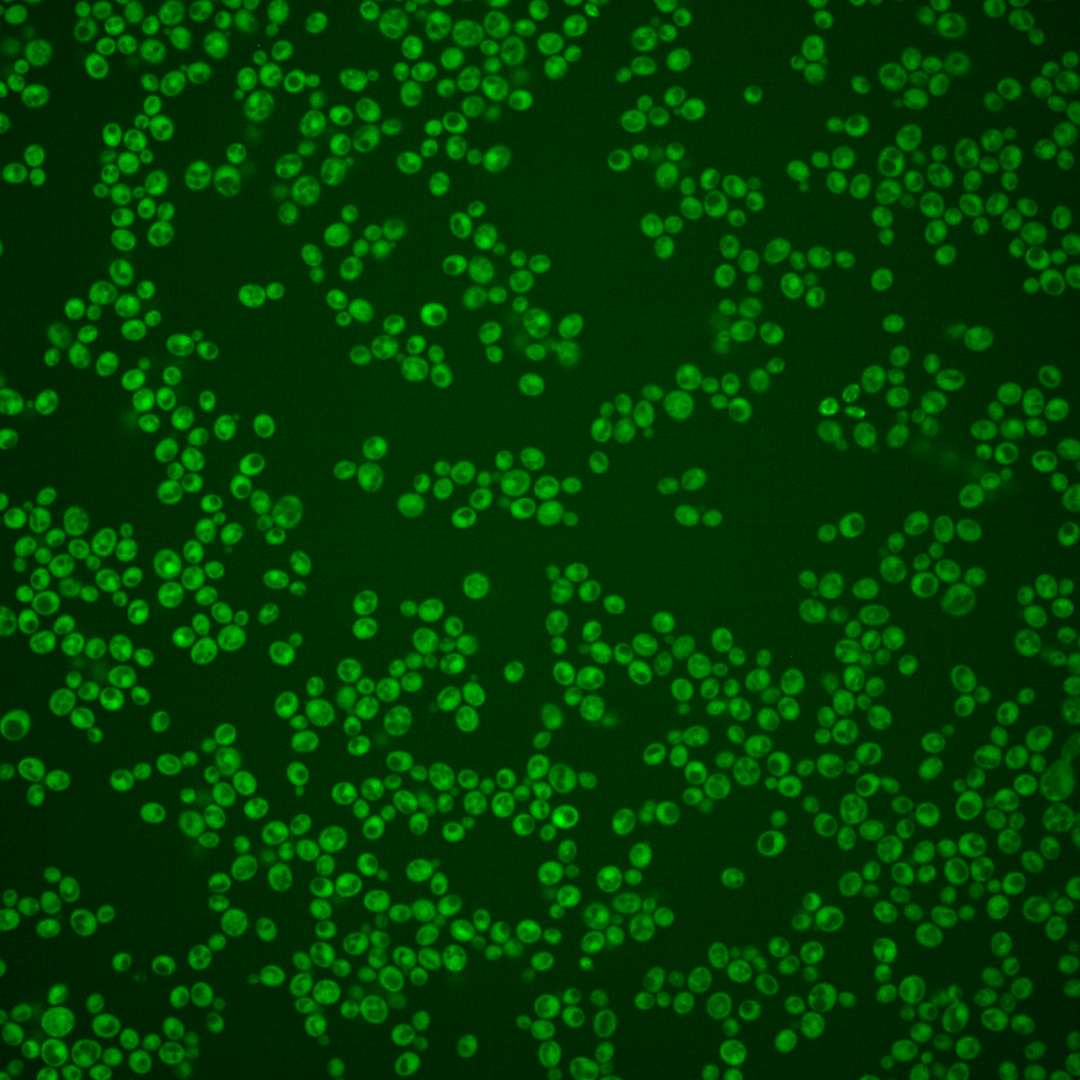
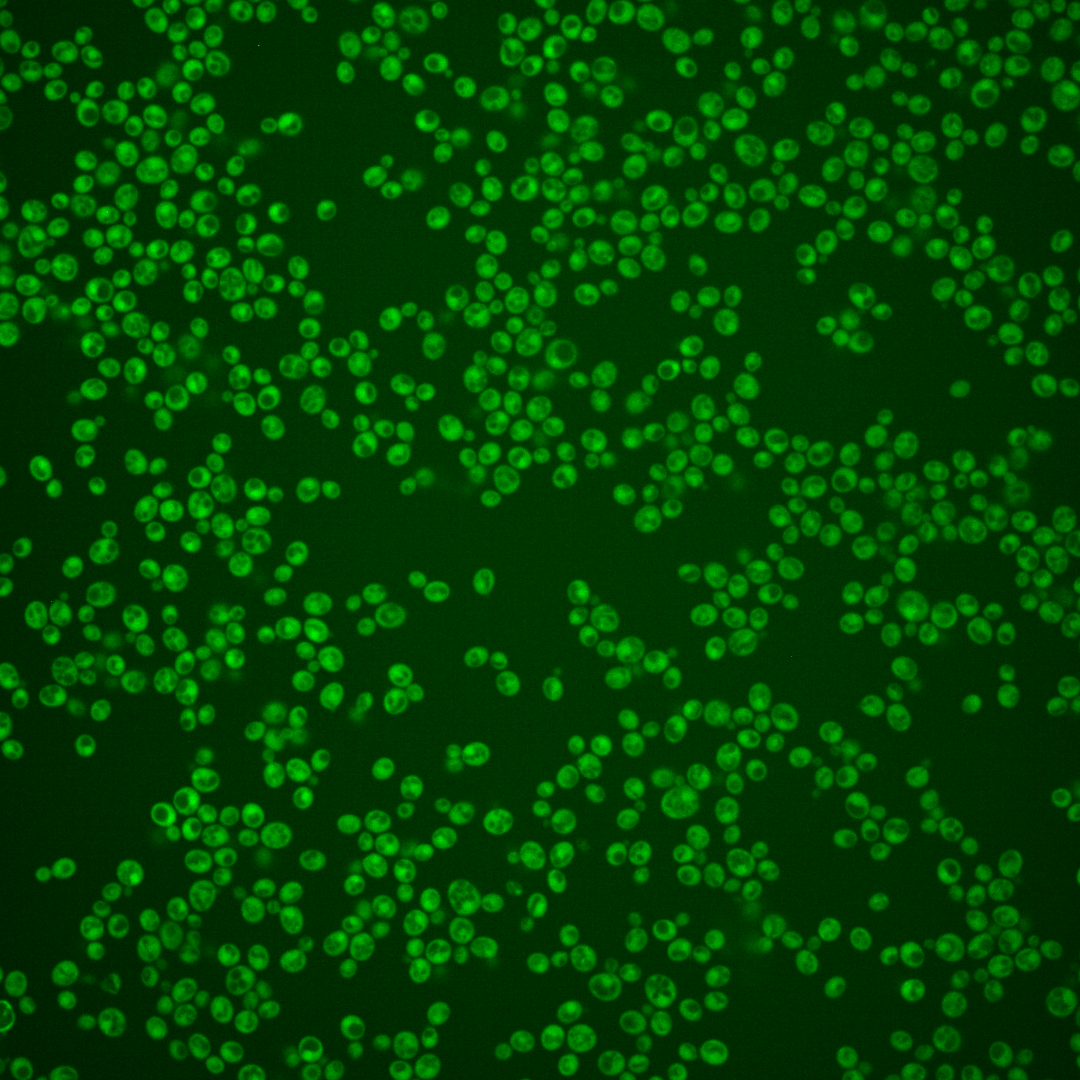

| Standard name | |
|---|---|
| Human Ortholog | |
| Description | Ornithine decarboxylase; catalyzes the first step in polyamine biosynthesis; degraded in a proteasome-dependent manner in the presence of excess polyamines; deletion decreases lifespan, and increases necrotic cell death and ROS generation |
Micrographs




















































































Sub-cellular Localization
Yeast GFP Assignment
Protein Abundance
Localization Change
External localization resources
| ensLOC | DeepLoc | |||||||||||||||||||||||
|---|---|---|---|---|---|---|---|---|---|---|---|---|---|---|---|---|---|---|---|---|---|---|---|---|
| Localization | WT1 | WT2 | WT3 | RAP60 | RAP140 | RAP220 | RAP300 | RAP380 | RAP460 | RAP540 | RAP620 | RAP700 | HU80 | HU120 | HU160 | rpd3Δ_1 | rpd3Δ_2 | rpd3Δ_3 | WT1 | WT2 | WT3 | AF100 | AF140 | AF180 |
| Cortical Patches | 0 | 0 | 0 | 0 | 0 | 0 | 0 | 0 | 0 | 0 | 0 | 0 | 0 | 0 | 0 | 0 | 0 | 0 | 0 | 0 | 2 | 0 | 1 | 5 |
| Bud | 1 | 1 | 1 | 1 | 2 | 0 | 2 | 1 | 1 | 2 | 3 | 5 | 1 | 0 | 0 | 0 | 0 | 1 | 0 | 0 | 0 | 3 | 2 | 15 |
| Bud Neck | 0 | 0 | 0 | 0 | 0 | 1 | 0 | 7 | 2 | 1 | 0 | 0 | 0 | 0 | 0 | 0 | 0 | 0 | 0 | 0 | 0 | 0 | 1 | 1 |
| Bud Site | 0 | 0 | 0 | 0 | 0 | 0 | 0 | 0 | 0 | 0 | 0 | 2 | 0 | 0 | 0 | 0 | 0 | 0 | – | – | – | – | – | – |
| Cell Periphery | 0 | 1 | 0 | 0 | 1 | 0 | 0 | 1 | 0 | 4 | 1 | 1 | 4 | 1 | 1 | 0 | 2 | 4 | 0 | 0 | 0 | 0 | 0 | 2 |
| Cytoplasm | 168 | 100 | 58 | 93 | 102 | 133 | 164 | 232 | 139 | 146 | 79 | 126 | 519 | 709 | 707 | 108 | 124 | 77 | 184 | 113 | 61 | 313 | 394 | 389 |
| Endoplasmic Reticulum | 0 | 0 | 1 | 1 | 0 | 0 | 0 | 1 | 0 | 0 | 1 | 0 | 4 | 3 | 2 | 6 | 14 | 2 | 1 | 0 | 0 | 2 | 1 | 4 |
| Endosome | 0 | 0 | 0 | 0 | 0 | 0 | 0 | 2 | 0 | 0 | 0 | 0 | 0 | 2 | 0 | 1 | 1 | 1 | 0 | 1 | 0 | 1 | 1 | 9 |
| Golgi | 0 | 0 | 0 | 0 | 0 | 0 | 0 | 0 | 0 | 0 | 0 | 0 | 0 | 0 | 1 | 0 | 1 | 0 | 0 | 0 | 0 | 0 | 1 | 1 |
| Mitochondria | 5 | 1 | 8 | 11 | 10 | 15 | 51 | 63 | 76 | 71 | 91 | 84 | 0 | 1 | 0 | 2 | 2 | 1 | 0 | 0 | 1 | 3 | 0 | 6 |
| Nucleus | 1 | 0 | 0 | 0 | 0 | 1 | 4 | 3 | 2 | 2 | 0 | 2 | 1 | 1 | 0 | 0 | 1 | 0 | 0 | 0 | 0 | 0 | 1 | 0 |
| Nuclear Periphery | 0 | 0 | 0 | 1 | 0 | 1 | 1 | 0 | 0 | 0 | 0 | 0 | 0 | 0 | 0 | 0 | 1 | 0 | 0 | 0 | 0 | 0 | 1 | 0 |
| Nucleolus | 0 | 0 | 0 | 1 | 0 | 0 | 1 | 0 | 0 | 0 | 0 | 0 | 0 | 0 | 0 | 0 | 0 | 0 | 0 | 0 | 0 | 0 | 0 | 0 |
| Peroxisomes | 0 | 0 | 0 | 0 | 0 | 0 | 0 | 0 | 0 | 0 | 0 | 0 | 0 | 0 | 0 | 0 | 0 | 0 | 0 | 0 | 0 | 0 | 0 | 0 |
| SpindlePole | 0 | 0 | 0 | 0 | 0 | 0 | 0 | 3 | 4 | 2 | 2 | 3 | 0 | 0 | 0 | 0 | 0 | 0 | 0 | 0 | 0 | 0 | 0 | 6 |
| Vac/Vac Membrane | 1 | 1 | 1 | 0 | 0 | 0 | 1 | 2 | 0 | 1 | 0 | 0 | 2 | 2 | 11 | 0 | 2 | 1 | 1 | 1 | 0 | 1 | 0 | 6 |
| Unique Cell Count | 172 | 102 | 65 | 100 | 105 | 136 | 187 | 268 | 179 | 179 | 139 | 175 | 525 | 716 | 716 | 110 | 129 | 80 | 190 | 121 | 74 | 333 | 409 | 455 |
| Labelled Cell Count | 176 | 104 | 69 | 108 | 115 | 151 | 224 | 315 | 224 | 229 | 177 | 223 | 531 | 719 | 722 | 117 | 148 | 87 | 190 | 121 | 74 | 333 | 409 | 455 |
Yeast GFP Assignment
Protein Abundance
| Screen | WT1 | WT2 | WT3 | RAP60 | RAP140 | RAP220 | RAP300 | RAP380 | RAP460 | RAP540 | RAP620 | RAP700 | HU80 | HU120 | HU160 | rpd3Δ_1 | rpd3Δ_2 | rpd3Δ_3 | AF100 | AF140 | AF180 |
|---|---|---|---|---|---|---|---|---|---|---|---|---|---|---|---|---|---|---|---|---|---|
| Mean Cell GFP Intensity (1e-4) | 4.8 | 5.8 | 4.2 | 4.4 | 3.8 | 3.2 | 3.0 | 3.2 | 2.8 | 2.6 | 2.9 | 2.7 | 10.2 | 11.5 | 11.8 | 5.1 | 6.2 | 5.8 | 5.5 | 6.1 | 6.0 |
| Std Deviation (1e-4) | 0.5 | 1.1 | 1.2 | 0.8 | 0.9 | 1.4 | 1.6 | 1.6 | 1.2 | 1.2 | 1.6 | 1.6 | 2.2 | 2.4 | 2.3 | 1.2 | 1.4 | 0.8 | 1.0 | 1.4 | 1.3 |
| Intensity Change (Log2) | – | – | – | 0.04 | -0.15 | -0.39 | -0.51 | -0.41 | -0.58 | -0.68 | -0.54 | -0.65 | 1.26 | 1.44 | 1.47 | 0.26 | 0.54 | 0.46 | 0.38 | 0.52 | 0.5 |
Localization Change
| Localization | RAP60 | RAP140 | RAP220 | RAP300 | RAP380 | RAP460 | RAP540 | RAP620 | RAP700 | HU80 | HU120 | HU160 | rpd3Δ_1 | rpd3Δ_2 | rpd3Δ_3 |
|---|---|---|---|---|---|---|---|---|---|---|---|---|---|---|---|
| Cortical Patches | 0 | 0 | 0 | 0 | 0 | 0 | 0 | 0 | 0 | 0 | 0 | 0 | 0 | 0 | 0 |
| Bud | 0 | 0 | 0 | 0 | 0 | 0 | 0 | 0 | 0 | 0 | 0 | 0 | 0 | 0 | 0 |
| Bud Neck | 0 | 0 | 0 | 0 | 0 | 0 | 0 | 0 | 0 | 0 | 0 | 0 | 0 | 0 | 0 |
| Bud Site | 0 | 0 | 0 | 0 | 0 | 0 | 0 | 0 | 0 | 0 | 0 | 0 | 0 | 0 | 0 |
| Cell Periphery | 0 | 0 | 0 | 0 | 0 | 0 | 0 | 0 | 0 | 0 | 0 | 0 | 0 | 0 | 0 |
| Cytoplasm | 0.8 | 2.1 | 2.6 | -0.3 | -0.6 | -2.0 | -1.4 | -4.6 | -2.8 | 5.0 | 5.7 | 5.2 | 2.6 | 1.9 | 1.7 |
| Endoplasmic Reticulum | 0 | 0 | 0 | 0 | 0 | 0 | 0 | 0 | 0 | 0 | 0 | 0 | 0 | 2.3 | 0 |
| Endosome | 0 | 0 | 0 | 0 | 0 | 0 | 0 | 0 | 0 | 0 | 0 | 0 | 0 | 0 | 0 |
| Golgi | 0 | 0 | 0 | 0 | 0 | 0 | 0 | 0 | 0 | 0 | 0 | 0 | 0 | 0 | 0 |
| Mitochondria | 0 | 0 | 0 | 0 | 0 | 0 | 0 | 0 | 0 | 0 | 0 | 0 | 0 | 0 | 0 |
| Nucleus | 0 | 0 | 0 | 0 | 0 | 0 | 0 | 0 | 0 | 0 | 0 | 0 | 0 | 0 | 0 |
| Nuclear Periphery | 0 | 0 | 0 | 0 | 0 | 0 | 0 | 0 | 0 | 0 | 0 | 0 | 0 | 0 | 0 |
| Nucleolus | 0 | 0 | 0 | 0 | 0 | 0 | 0 | 0 | 0 | 0 | 0 | 0 | 0 | 0 | 0 |
| Peroxisomes | 0 | 0 | 0 | 0 | 0 | 0 | 0 | 0 | 0 | 0 | 0 | 0 | 0 | 0 | 0 |
| SpindlePole | 0 | 0 | 0 | 0 | 0 | 0 | 0 | 0 | 0 | 0 | 0 | 0 | 0 | 0 | 0 |
| Vacuole | 0 | 0 | 0 | 0 | 0 | 0 | 0 | 0 | 0 | 0 | 0 | 0 | 0 | 0 | 0 |
External localization resources
Images






























Protein Concentration and Protein Localization Data
| R1 | R2 | R3 | ||||||||||||||||
|---|---|---|---|---|---|---|---|---|---|---|---|---|---|---|---|---|---|---|
| G1 Pre-START | G1 Post-START | S/G2 | Metaphase | Anaphase | Telophase | G1 Pre-START | G1 Post-START | S/G2 | Metaphase | Anaphase | Telophase | G1 Pre-START | G1 Post-START | S/G2 | Metaphase | Anaphase | Telophase | |
| Concentration | 5.0164 | 5.4353 | 5.2323 | 4.9921 | 5.3177 | 5.4589 | 1.8272 | 1.6628 | 3.4125 | 3.621 | 2.6786 | 3.0389 | 3.4048 | 3.5983 | 3.2164 | 3.7885 | 3.1269 | 3.4007 |
| Actin | 0.0866 | 0.0003 | 0.0149 | 0.0131 | 0.0002 | 0.0111 | 0.2266 | 0.0267 | 0.0003 | 0.0012 | 0.0002 | 0.0058 | 0.0481 | 0.0018 | 0.0102 | 0.0106 | 0.0126 | 0.0015 |
| Bud | 0.0008 | 0.0035 | 0.0092 | 0.0017 | 0.0001 | 0.0012 | 0.0013 | 0.0004 | 0.0001 | 0.0002 | 0 | 0.0001 | 0.0014 | 0.0007 | 0.0007 | 0.002 | 0.001 | 0.0001 |
| Bud Neck | 0.0025 | 0.0001 | 0.0013 | 0.0007 | 0.0002 | 0.0029 | 0.0006 | 0.0002 | 0 | 0.0001 | 0.0001 | 0.0007 | 0.0003 | 0.0003 | 0.0041 | 0.0002 | 0.001 | 0.0004 |
| Bud Periphery | 0.0011 | 0.0008 | 0.0026 | 0.0011 | 0.0001 | 0.0015 | 0.0035 | 0.0002 | 0 | 0.0001 | 0 | 0.0001 | 0.0014 | 0.0006 | 0.0009 | 0.002 | 0.0025 | 0.0001 |
| Bud Site | 0.0033 | 0.0053 | 0.0031 | 0.0018 | 0.0001 | 0.0008 | 0.0013 | 0.0012 | 0.0003 | 0.0003 | 0 | 0.0012 | 0.0016 | 0.0067 | 0.0089 | 0.0006 | 0.0082 | 0 |
| Cell Periphery | 0.0004 | 0.0002 | 0.0002 | 0.0001 | 0 | 0.0002 | 0.0005 | 0.0001 | 0.0001 | 0.0001 | 0 | 0.0001 | 0.0002 | 0.0002 | 0.0002 | 0.0001 | 0.0005 | 0 |
| Cytoplasm | 0.4843 | 0.817 | 0.7349 | 0.5248 | 0.7103 | 0.7868 | 0.0134 | 0.5829 | 0.3445 | 0.4994 | 0.7283 | 0.6414 | 0.4583 | 0.64 | 0.6242 | 0.4728 | 0.5209 | 0.6221 |
| Cytoplasmic Foci | 0.0169 | 0.0045 | 0.0144 | 0.0362 | 0.008 | 0.0093 | 0.0108 | 0.0183 | 0.0053 | 0.0358 | 0.0019 | 0.0277 | 0.016 | 0.0086 | 0.0065 | 0.0325 | 0.0192 | 0.0077 |
| Eisosomes | 0.0005 | 0 | 0.0016 | 0.0002 | 0.0001 | 0.0001 | 0.0067 | 0.0001 | 0.0001 | 0.0001 | 0 | 0.0003 | 0.0004 | 0.0001 | 0.0001 | 0.0001 | 0.0008 | 0 |
| Endoplasmic Reticulum | 0.0183 | 0.0018 | 0.0038 | 0.0033 | 0.0027 | 0.0067 | 0.0077 | 0.0029 | 0.0029 | 0.0024 | 0.0012 | 0.0012 | 0.0075 | 0.0049 | 0.0022 | 0.006 | 0.0021 | 0.0023 |
| Endosome | 0.0251 | 0.0022 | 0.008 | 0.0021 | 0.0038 | 0.0107 | 0.0302 | 0.0031 | 0.0016 | 0.1549 | 0.0004 | 0.0031 | 0.0191 | 0.0015 | 0.0078 | 0.0055 | 0.012 | 0.0018 |
| Golgi | 0.0082 | 0.0002 | 0.0026 | 0.0014 | 0.0001 | 0.0015 | 0.0309 | 0.0013 | 0.0002 | 0.0428 | 0 | 0.0019 | 0.0026 | 0.0004 | 0.0059 | 0.001 | 0.0033 | 0.0002 |
| Lipid Particles | 0.0076 | 0.0001 | 0.0058 | 0.0085 | 0.0002 | 0.0007 | 0.0478 | 0.0002 | 0.0008 | 0.0044 | 0 | 0.0064 | 0.0037 | 0.0006 | 0.0004 | 0.001 | 0.0312 | 0.0002 |
| Mitochondria | 0.0026 | 0.0002 | 0.0012 | 0.0013 | 0.0001 | 0.0161 | 0.0236 | 0.0005 | 0.0001 | 0.003 | 0.0001 | 0.0021 | 0.0013 | 0.0002 | 0.0014 | 0.0005 | 0.052 | 0.0001 |
| None | 0.2898 | 0.1599 | 0.17 | 0.2973 | 0.2704 | 0.1369 | 0.5359 | 0.3547 | 0.6407 | 0.2494 | 0.2644 | 0.2947 | 0.414 | 0.3256 | 0.3226 | 0.4481 | 0.3079 | 0.3604 |
| Nuclear Periphery | 0.024 | 0.0005 | 0.0043 | 0.0015 | 0.0007 | 0.0035 | 0.0153 | 0.0013 | 0.0007 | 0.0008 | 0.0004 | 0.0002 | 0.0064 | 0.0012 | 0.0005 | 0.0024 | 0.0005 | 0.0005 |
| Nucleolus | 0.0005 | 0.0001 | 0.0004 | 0.0002 | 0 | 0.0002 | 0.0009 | 0.0001 | 0.0001 | 0.0001 | 0 | 0.0001 | 0.0004 | 0.0002 | 0.0001 | 0.0001 | 0.0054 | 0 |
| Nucleus | 0.0066 | 0.0014 | 0.0051 | 0.0016 | 0.0011 | 0.0039 | 0.0012 | 0.0014 | 0.0008 | 0.0005 | 0.0024 | 0.0004 | 0.0032 | 0.0017 | 0.0009 | 0.0017 | 0.0012 | 0.0011 |
| Peroxisomes | 0.0058 | 0 | 0.0076 | 0.0948 | 0.0001 | 0.0007 | 0.0311 | 0.0022 | 0.0001 | 0.0013 | 0 | 0.0115 | 0.002 | 0.0003 | 0.0012 | 0.0038 | 0.0087 | 0.0002 |
| Punctate Nuclear | 0.0119 | 0.0004 | 0.0076 | 0.0075 | 0.0004 | 0.0012 | 0.005 | 0.0013 | 0.0005 | 0.0004 | 0.0003 | 0.0005 | 0.0105 | 0.0035 | 0.0003 | 0.0077 | 0.0066 | 0.0008 |
| Vacuole | 0.002 | 0.0015 | 0.001 | 0.0007 | 0.001 | 0.003 | 0.0014 | 0.0008 | 0.0008 | 0.0015 | 0.0002 | 0.0004 | 0.0012 | 0.0007 | 0.0007 | 0.0009 | 0.002 | 0.0003 |
| Vacuole Periphery | 0.0013 | 0.0001 | 0.0003 | 0.0002 | 0.0002 | 0.001 | 0.0043 | 0.0002 | 0.0001 | 0.0013 | 0 | 0.0001 | 0.0005 | 0.0001 | 0.0002 | 0.0003 | 0.0005 | 0 |
Sequencing Data
| R1 | R2 | |||||||||
|---|---|---|---|---|---|---|---|---|---|---|
| G1 Post-START | S/G2 | Metaphase | Anaphase | Telophase | G1 Post-START | S/G2 | Metaphase | Anaphase | Telophase | |
| Gene Expression | 113.0182 | 117.5766 | 117.5482 | 106.03 | 103.1348 | 104.6906 | 120.1273 | 123.4786 | 111.3538 | 108.1132 |
| Translational Efficiency | 1.1651 | 1.1141 | 1.0 | 1.0589 | 0.8406 | 1.4049 | 1.1178 | 0.9618 | 1.0423 | 0.9284 |
Hit Data
| Dataset | Hit |
|---|---|
| Protein Concentration | ✘ |
| Protein Localization | ✘ |
| Gene Expression | ✔ |
| Translational Efficiency | ✘ |
Endocytosis
| Temp | Actin Patch (Sac6-tdTomato) | Cortical Patch (Sla1-GFP) | Late Endosome (Snf7-GFP) | Vacuole (Vph1-GFP) |
|---|---|---|---|---|
| 37℃ | ||||
| RT |
Cell Cycle Omics
CYCLoPs (Spe1-GFP)
| Gene / Allele | Actin Patch (Sac6-tdTomato) | Cortical Patch (Sla1-GFP) | Late Endosome (Snf7-GFP) | Vacuole (Sac6-tdTomato) |
|---|
| Gene | Images |
|---|
| Gene | Images |
|---|
Images are not yet available
Images are not yet available